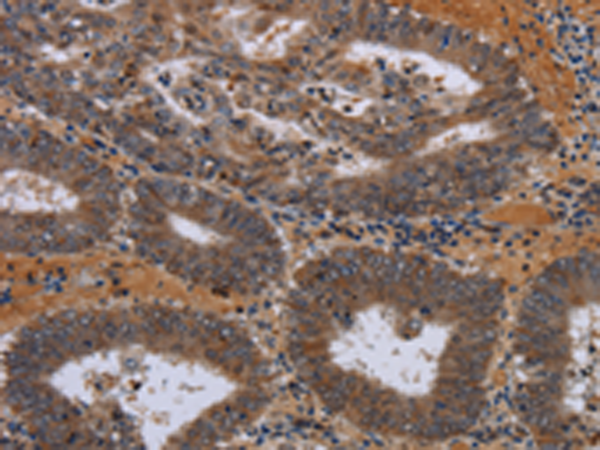

中文名稱: 兔抗JMJD7多克隆抗體
|
Background: |
This gene encodes a highly conserved protein with a JmjC domain, which are part of the cupin metalloenzyme superfamily. JmjC proteins may function as 2-oxoglutarate-Fe(II)-dependent dioxygenases. Most tissues also express read-through transcripts from this gene into the downstream phospholipase A2, group IVB (cytosolic) gene, some of which may encode fusion proteins combining the N-terminus of this protein with the phospholipase A2, group IVB protein. |
|
Applications: |
ELISA, IHC |
|
Name of antibody: |
JMJD7 |
|
Immunogen: |
Fusion protein of human JMJD7 |
|
Full name: |
jumonji domain containing 7 |
|
SwissProt: |
P0C870 |
|
ELISA Recommended dilution: |
2000-5000 |
|
IHC positive control: |
Human colon cancer |
|
IHC Recommend dilution: |
50-200 |
購物車
購物車 幫助
幫助
 021-54845833/15800441009
021-54845833/15800441009
